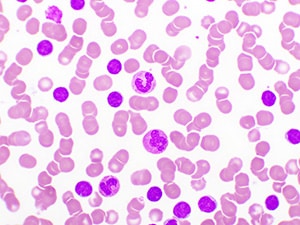

Noncovalent BTK Inhibitor Granted Traditional Approval for Certain Lymphomas
Pirtobrutinib was approved for certain relapsed/refractory chronic lymphocytic leukemias or small lymphocytic lymphomas.
The U.S. Food and Drug Administration (FDA) has granted traditional approval to pirtobrutinib (Jaypirca) for adults with relapsed or refractory chronic lymphocytic leukemia or small lymphocytic lymphoma (CLL/SLL) who have previously been treated with a covalent Bruton tyrosine kinase (BTK) inhibitor.
Pirtobrutinib is an inhibitor of BTK, a protein that helps B cells survive and communicate. In CLL/SLL, cancerous B cells can depend on BTK signaling to proliferate. BTK inhibitors work by blocking BTK, helping slow or stop the growth of malignant B cells. Pirtobrutinib is different from earlier BTK inhibitors because it is reversible—it binds BTK in a way that doesn’t rely on permanently attaching to the protein and is the first BTK inhibitor with this feature. Because pirtobrutinib binds to BTK in a different way than other BTK inhibitors, it may benefit patients whose cancers have become resistant to other BTK inhibitors.
The FDA granted accelerated approval to pirtobrutinib in December 2023 to treat adults with CLL/SLL who had received at least two prior lines of therapy, including a BTK inhibitor and a BCL-2 inhibitor. This latest FDA decision converts that accelerated approval to a traditional approval and removes the requirement for prior treatment with a BCL-2 inhibitor.
The conversion of the accelerated approval to a traditional approval was based on the results of BRUIN CLL‑321, a randomized, open‑label, active‑controlled phase III trial enrolling 238 patients with previously treated CLL/SLL who had already received a covalent BTK inhibitor. Patients were randomly assigned (1:1) to receive either pirtobrutinib or the physician’s choice of standard therapy—idelalisib (Zydelig) plus rituximab (Rituxan) or bendamustine (Bendeka) plus rituximab—and patients in the standard therapy group were allowed to switch over to pirtobrutinib if they experienced disease progression. The efficacy of the drug was assessed by progression-free survival (PFS), which is the length of time before the disease gets worse or the patient dies.
In the study, patients taking pirtobrutinib had a median PFS of 11.2 months, compared with 8.7 months for those receiving standard therapy. Patients in the pirtobrutinib arm were 42% less likely to have their disease worsen or to die during the median follow-up time of 6.6 months than patients in the standard therapy arm. Of the 119 patients in the standard therapy arm, 50 crossed over to receive pirtobrutinib.
The recommended dose of pirtobrutinib is 200 mg orally once daily until the patient experiences disease progression or unacceptable toxicity.
CLL and SLL are both comprised of malignant B lymphocytes, but they are distinguished by where most of the cancer cells are found—primarily in blood or bone marrow in CLL versus primarily in lymph nodes in SLL. Between 2018 and 2022 in the United States, the age-adjusted incidence and mortality rates of CLL/SLL were 4.5 per 100,000 individuals and 0.8 per 100,000 individuals, respectively.
The FDA rendered its decision on December 3, 2025. Check this resource for updated information on all therapeutics regulated by the FDA.